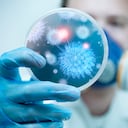
Un científico sostiene una placa con virus y células bacterianas

SALUD
El virus Langya que apareció en China: ¿es o no una amenaza?
El nuevo virus Langya se ha descubierto durante un estudio rutinario de vigilancia epidemiológica. Se tomaron muestras de hisopados de garganta y se secuenció todo el material genético de la muestra.
Siga las noticias de SEMANA en Google Discover y manténgase informado

Hace unas semanas fue noticia en muchos medios internacionales el descubrimiento de un nuevo virus en China: el virus Langya. Probablemente esta noticia hubiera pasado desapercibida hace años si no fuera porque ahora todos estamos muy sensibles con esto de los virus, las pandemias y los chinos.
En realidad, la búsqueda y el descubrimiento de nuevos virus es algo muy frecuente, sobre todo desde que tenemos las nuevas herramientas de metagenómica que permiten amplificar y detectar cualquier nueva secuencia genómica en cualquier muestra.
Una larga lista de recién llegados
El virólogo Miguel Ángel Jiménez Clavero recoge en su cuenta de Twitter (@Virusemergentes) algunos ejemplos de los nuevos virus descubiertos en los últimos años:
- El arenavirus Ocozocoautla hallado en México en 2013.
- El virus Bourbon, un nuevo orthomyxovirus transmitido por garrapatas descrito en EE. UU. en 2014.
- El virus Itaya, asociado a fiebres humanas en Perú en 2015.
- El paramyxovirus Sosuga, causante de fiebres hemorrágicas en Sudán en 2016.
- El filovirus Mengla (similar al del Ébola y el de Marburg), hallado en murciélagos en China en 2019.
- El nuevo orthoreovirus de patos N-DRV, descrito en China en 2020.
- El Lanama virus, un nuevo picornavirus descubierto en monos en Uganda en 2020.
- El virus Songling, descrito por primera vez en China en 2021 y asociado a enfermedades febriles en humanos.
Inesperadamente este hilo sobre el nuevo virus #Langya ha tenido mucho eco. Muchos habéis expresado cansancio, enfado, o cosas peores, contra los virus, contra China, contra las musarañas... Para tranquilizaros voy a desarrollar otro hilo a continuación 🧵 https://t.co/6ewDR3SqtJ
— Virusemergentes (@Virusemergentes) August 11, 2022
El descubrimiento de nuevos virus ocurre en cualquier lugar del mundo (México, EE. UU., Perú, Sudán, China, Uganda…) y la característica común es que todos ellos proceden del mundo animal, son zoonóticos: enfermedades de los animales que saltan al ser humano o viceversa. Son lo que podríamos denominar derrames zoonóticos.
Así salió a la luz
El nuevo virus Langya se ha descubierto durante un estudio rutinario de vigilancia epidemiológica. Este consistía en reclutar pacientes con historial de fiebre de origen desconocida en tres hospitales de las provincias de Shandong y Henan, en el este de China, entre abril de 2018 y agosto de 2021. Se tomaron muestras de hisopados de garganta y se secuenció todo el material genético de la muestra.
La detección se ha realizado por métodos metagenómicos (extracción del ARN total, secuenciación, alineamiento de secuencias y ensamblaje) y aislamiento del virus. El primer paciente donde se encontró su genoma era una mujer de 53 años que vivía en la ciudad de Langya; por eso se ha denominado virus Langya.
A lo largo de los más de tres años que duró el estudio, los investigadores encontraron a 35 personas infectadas con Langya. En su mayoría, agricultores que habían estado expuestos a animales en el plazo de un mes antes de que aparecieran sus síntomas, que iban desde neumonía grave hasta tos. Los síntomas más frecuentes eran fiebre, tos y fatiga. En 26 de los 35 pacientes el único patógeno potencial que se encontró fue el virus Langya.
Ni brote ni mortal
No se ha descrito ningún fallecimiento, por lo que de momento no parece que sea mortal para el ser humano. No existía ninguna vinculación o relación epidemiológica entre los 35 pacientes. No hay casos en la misma familia o en sitios geográficamente muy próximos. No hay datos que sugieran una transmisión entre personas. Por todo ello, esto no puede considerarse un brote epidemiológico concreto. Es un estudio retrospectivo de casos aislados durante tres años consecutivos.

El genoma de Langya muestra que el virus está estrechamente relacionado con el henipavirus de Mojiang, que se aisló por primera vez en ratas en una mina abandonada en la provincia de Yunnan, en el sur de China, en 2012. Los henipavirus pertenecen a la familia Paramyxoviridae, que incluye el sarampión, las paperas y muchos otros virus respiratorios que infectan a personas.
Se han descubierto otros henipavirus en murciélagos, ratas y musarañas, desde Australia hasta Corea del Sur y China. Hasta ahora, los únicos henipavirus que se sabe que infectan a las personas eran el virus Hendra y el Nipah, que causan también infecciones respiratorias y pueden incluso llegar a ser mortales.
Posiblemente saltó de las musarañas
Para determinar el posible origen animal de este virus, los investigadores analizaron la presencia de anticuerpos contra el virus en la sangre de 168 cabras, 79 perros, 112 cerdos y 100 vacas que viven en las aldeas de los pacientes infectados. Solo 4 perros y 3 cabras dieron positivo.
Además, tomaron muestras de tejidos y de orina de 25 especies de pequeños animales salvajes para buscar la presencia del genoma del virus por técnicas moleculares. Tras analizar un total de 3 380 muestras, detectaron el ARN del virus en el 27 % de las 262 musarañas estudiadas (no en todas las especies; en concreto, en Crocidura lasiura y Crocidura shantungensis). Estos datos sugieren que quizá este tipo de musarañas podrían ser el reservorio o almacén del virus, que directamente o a través de otros animales domésticos podría infectar a las personas, siendo el ser humano un hospedador accidental.
De momento, no hay motivo para la alarma, ya que no existe ningún dato o indicio que sugiera que este nuevo virus pudiera suponer una amenaza pandémica. Lo que el artículo pone de manifiesto es la necesidad de un sistema de vigilancia global para detectar los efectos indirectos de nuevos virus. No sabemos cuándo será la próxima pandemia –la covid-19 no ha sido la última (todavía no ha terminado) ni la peor (podría haber sido mucho más mortífera)–, pero de lo que sí estamos seguros es de que habrá otra y de que con toda probabilidad vendrá del mundo animal.
En el futuro próximo, la única estrategia posible solo puede estar basada en el concepto One Health (una sola salud o salud global), en el que se coordinen la vigilancia y los esfuerzos en salud humana, salud animal y salud ambiental. Conocer qué pasa en el mundo animal nos prevendrá de futuras amenazas.
Una versión de este artículo fue publicada originalmente en el blog del autor, microBIO.
Por: Ignacio López-Goñi
Catedrático de Microbiología, Universidad de Navarra
Artículo publicado en The Conversation